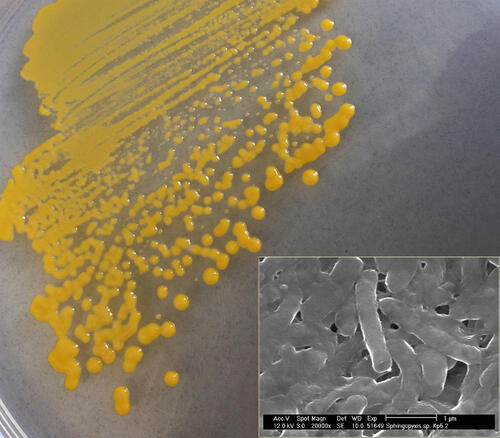
Bakterienkolonien der entdeckten Art Sphingopyxis fribergensis auf einem glukosehaltigen Kulturmedium; Rasterelektronenmikroskopische Nahaufnahme der Bakterienzellen  © TU Bergakademie Freiberg / Michel Oelschlägel, Gert Schmidt

Bild-Download
Bilddownload / Anzeige der großen Version:
Das Bild können Sie auf dieser Seite in einer hochwertigen Version herunterladen. Lesen Sie bitte vorher die rechtlichen Bestimmungen. Mit dem Download stimmen sie diesen Bestimmungen zu!
Rechtliches:
Die Verwendung dieses Bildes ist ausschließlich im Rahmen redaktioneller Berichterstattung mit inhaltlichen Bezügen zur Deutschen Bundesstiftung Umwelt (DBU) erlaubt. Das Bild kann zu diesem Zweck vervielfältigt und kostenlos veröffentlicht werden. Alle angebotenen Bilder durch die Bilddatenbank piclease dürfen nicht für die Sozialen Medien verwendet werden. Die Bearbeitung des Bildes ist nicht erlaubt. Verkleinerungen oder Vergrößerungen, die der technischen Aufbereitung zum Zweck der optimalen Vervielfältigung dienen, sowie eine den zentralen Sinn des Bildes nicht entstellende Ausschnittwahl sind zulässig.
Copyright:
© TU Bergakademie Freiberg / Michel Oelschlägel, Gert Schmidt

Bakterienkolonien der entdeckten Art Sphingopyxis fribergensis auf einem glukosehaltigen Kulturmedium; Rasterelektronenmikroskopische Nahaufnahme der Bakterienzellen
Max. Druckgröße für dieses Bild:
200 dpi: 26 cm x 23 cm (Zeitungen)
300 dpi: 17 cm x 15 cm (Magazine)
Abmessungen: 2008 x 1758 Pixel - 2477.62 kb
Ich habe die rechtlichen Hinweise akzeptiert & möchte das Bild herunterladen
Zurück zum Text